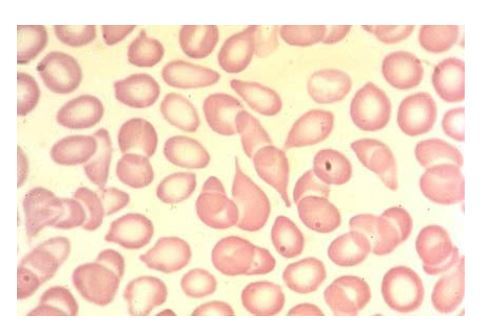
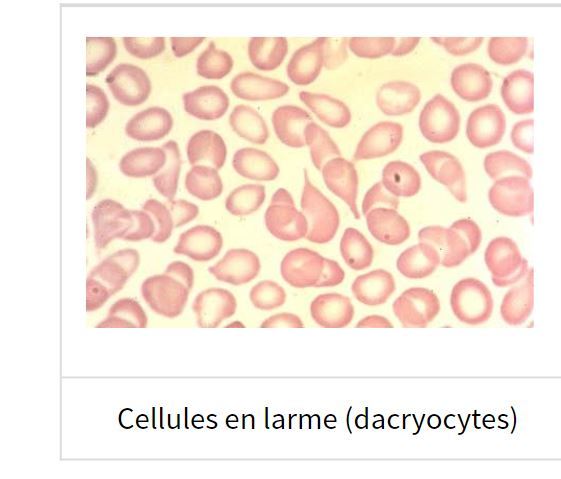
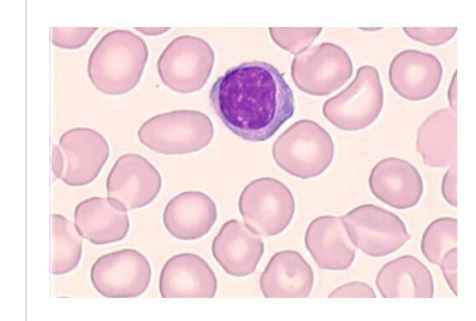
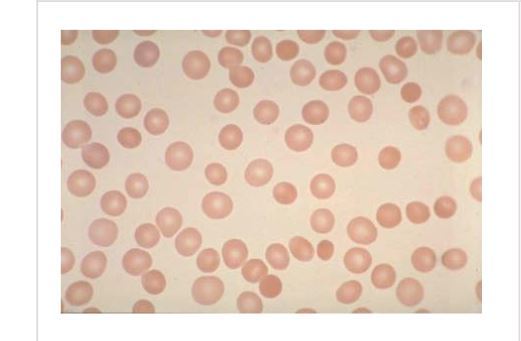
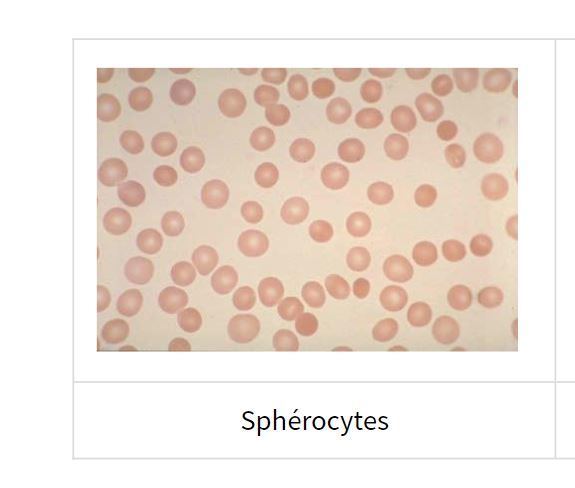
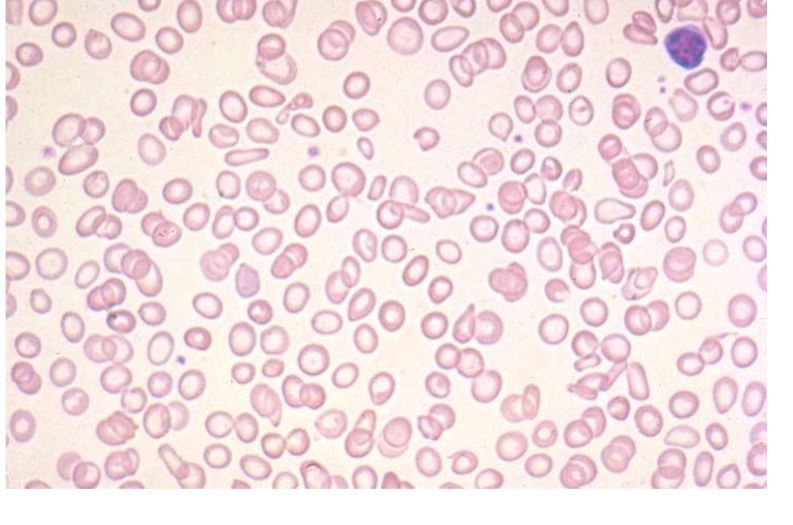
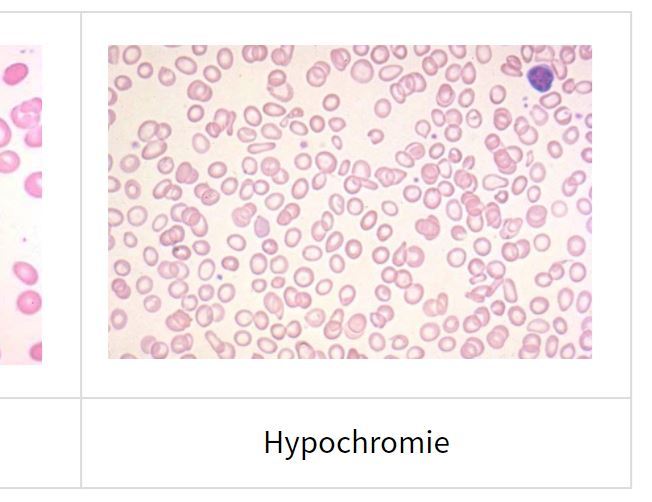
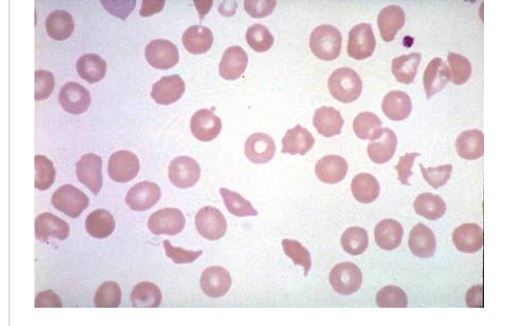
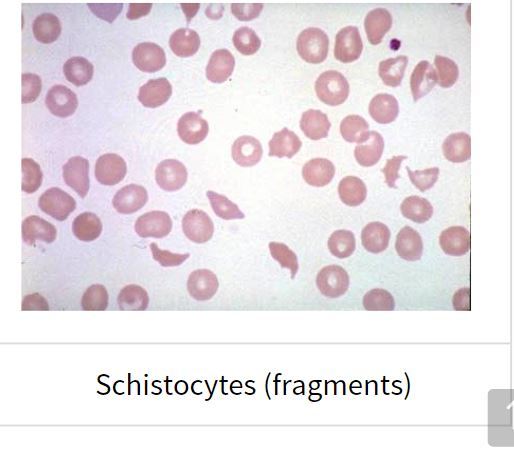
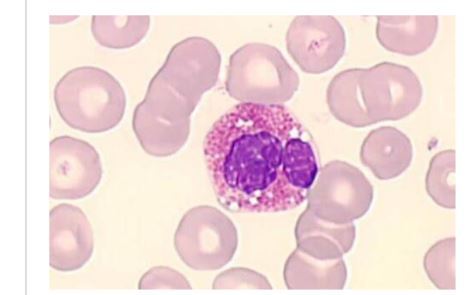
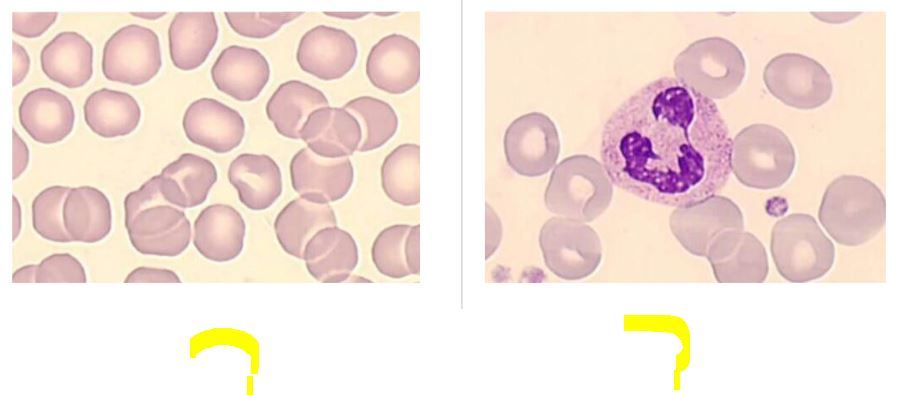
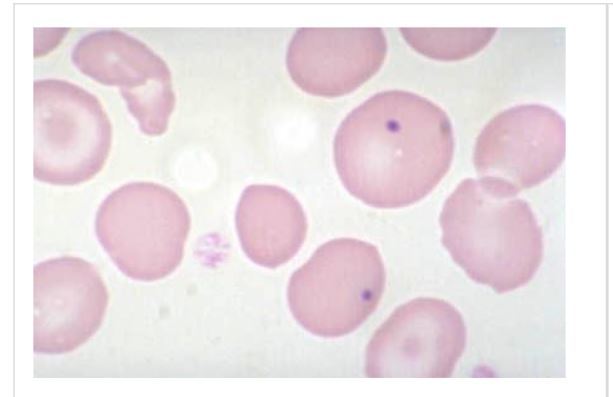
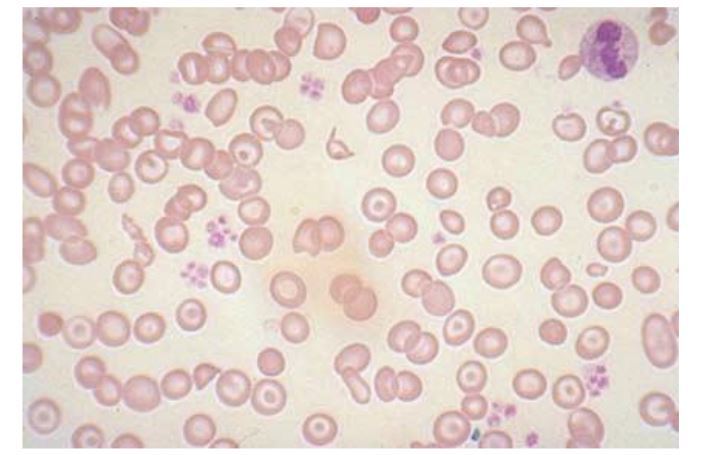
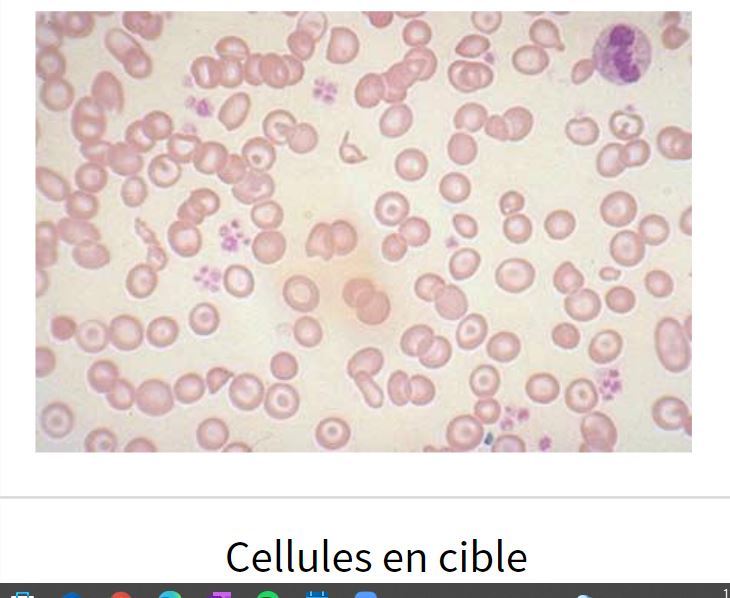

ENCOCHÉ , MAIS NON POLYLOBÉ!;)

dans quelles pathos t’attends tu a avoir des macro-ovalocytes et qu’est ce que tu t’attends à voir aussi
anémie MÉGALOBLASTIQUE ( b12 , folates)
et risque d’avoir PMN HYPERSEGMENTÉ!!!

dans quelle patho est ce que tu retrouverais des dacryocytes
–) means cellules en larmme
ca veut dire que envahissement de la moelle ++++
penser à myélofibrose!!

donne au moins une patho que tu devrais suspecter
bah ya envahissement moelle
penser entre autre à MYÉLOFIBROSE

un beau basophile waouh
( noyau masqué quasiment par les grosses granulations)

à part sphérocytose héréditaire , dans quelle circonstances que tu pourrais avoir sphérocytes
ANémie par HÉMOLYSE AUTOIMMUNE!!

Noyau prend presque tout la place et cellule bien arrondie
—) PETIT LYMPHOCYTE

je pense que ya microcytose , mais ouin clairement hypochromie pck disque blanc bcp trop grand
tu vois des schistocytes , ca doit te faire suspecter quoi
je sais pas c’est quoi MAHA
faque entk je veux au moins que tu penses à
HÉMOLYSE MÉCANIQUE( genre valve)



donne 3 circonstances qui peuvent causer des cellules cibles
Thalassémie
maladie HÉPATIQUE
ASPLÉNIE

donne au moins une patho que tu dois suspecter
HÉMOLYSE INTRAVASCULAIRE MÉCANIQUE

c’est un bel éosinophile
waouh

comment se nomme les cellules à droite , et qu’est ce qui peut faire que érythrocyte devienne dememe

ÉCHINOCYTES
Si le PH AUGMENTE!!!!

c’est un signe de quoi? et comment ca s’appelle
corps de howell joly
signe de DYSFONCTION DE LA RATE


t,es clarement en anémie mégaloblastique